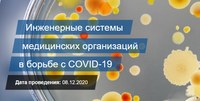

|
 Раздел: Электротехнический портал PowerPortal /
Новости Раздел: Электротехнический портал PowerPortal /
Новости
|
 |
|
Новости компании ООО Группа Legrand Россия и СНГВсего новостей: 112
Показано с 66 по 70
Страница: 14
Группа Legrand анонсирует очередную серию зимних вебинаров. С 4 по 11 февраля пройдут три ...
Группа Legrand анонсирует очередную серию зимних вебинаров. С 4 по 11 февраля пройдут три мероприятия, в рамках которых эксперты учебного центра поделятся решениями Группы для организации офисного пространства, представят щитки для модульного оборудования и устройства защиты от импульсных перенапряжений. В четверг, 4 февраля, состоится первый вебинар на тему «Решения Legrand – всё для организации офиса». Ведущий специалист учебного центра расскажет о продукции Группы для создания комфортного и эффективного офисного пространства. 9 февраля, в рамках обучения «Оболочки (щитки) для модульного оборудования», представитель Legrand подробно расскажет о сериях, особенностях монтажа, областях применения, преимуществах этих изделий ...Далее»
Автор: ООО Группа Legrand Россия и СНГ Дата: 03-02-2021
|
 Группа Legrand запускает в России линейку умных климатических устройств: метеостанцию с модулями ... Группа Legrand запускает в России линейку умных климатических устройств: метеостанцию с модулями ...
Группа Legrand запускает в России линейку умных климатических устройств: метеостанцию с модулями измерения количества осадков и скорости ветра, а также станцию мониторинга качества воздуха в помещении. Новые модели уже доступны к продаже. Они являются частью расширенного портфолио IoT-продукции бренда Netatmo и позволяют получить точные данные о погоде на улице и домашнем микроклимате, а также создать максимально комфортные условия для профилактики вирусных заболеваний. Продвинутая метеостанция у вас дома Метеостанция Legrand точно измеряет климатические и другие параметры окружающей среды каждые пять минут, составляет графики их изменений и прогнозы погоды. Если какой-либо показатель отклонится от нормы, система предупредит об этом пользователя с помощью уведомления. Собранные данные, статистика и прогнозы в простом и понятном виде отображаются на смартфоне, планшете или компьютере ...Далее»
Автор: ООО Группа Legrand Россия и СНГ Дата: 02-02-2021
|
Группа Legrand продолжает цикл обучений для партнеров и на этот раз проведет три вебинара подряд. С ...
Группа Legrand продолжает цикл обучений для партнеров и на этот раз проведет три вебинара подряд. С 8 по 10 декабря эксперты компании расскажут об умных щитах и щитках, обновленных зарядных устройствах Legrand и принципах подбора модульных защитно-коммутационных устройств. Во вторник, 8 декабря, пройдет вебинар «Умные щиты и щитки: модульная система энергетического менеджмента CX³ EMS». Представитель Legrand подробно расскажет о функционале системы, об ее эффективности для оптимизации энергопотребления, а также об особенностях установки, настройки и эксплуатации такого оборудования. 9 декабря, в среду, пройдет мероприятие «Последние обновления зарядных устройств Legrand», в рамках которого будут презентованы актуальные новинки Группы в этой сфере. Завершится серия вебинаров на тему «Как выбирать модульные защитно-коммутационные устройства серий RX³, TX³, DX³» ...Далее»
Автор: ООО Группа Legrand Россия и СНГ Дата: 08-12-2020
|
Группа Legrand примет участие в форуме специалистов ABOK «Инженерные системы медицинских ... Группа Legrand примет участие в форуме специалистов ABOK «Инженерные системы медицинских ...
Группа Legrand примет участие в форуме специалистов ABOK «Инженерные системы медицинских организаций в борьбе с COVID-19» в рамках «Российской недели здравоохранения 2020». Мероприятие пройдет 8 декабря в формате онлайн. Руководитель по работе с корпоративными клиентами Legrand Иван Романович представит решения и технологии бренда для объектов здравоохранения. Презентация «Технологии и решения Legrand, как поддержка медицинских учреждений» пройдет с 14:25 до 15:00 по московскому времени на онлайн-площадке форума. Иван подробно расскажет об оснащении объектов в рамках государственных национальных проектов «Столичное здоровье» и «Цифровизация медицины», а также поделится эффективными решениями для обеспечения бесперебойного питания в медицинских центрах, на примере выбора и поставки оборудования для ФГБУ НМИЦ им. В.А. Алмазова ...Далее»
Автор: ООО Группа Legrand Россия и СНГ Дата: 03-12-2020
|
АО «Контактор», бренд Группы Legrand, принял у себя на производстве студентов Корпоративного ...
АО «Контактор», бренд Группы Legrand, принял у себя на производстве студентов Корпоративного университета Ульяновской области, обучающихся по Президентской программе подготовки управленческих кадров. В ходе визита гости ознакомились с производственной системой предприятия и оценили опыт внедрения бережливых технологий. АО «Контактор» имеет богатую экспертизу в области применения различных инструментов бережливого производства. Специалисты компании подробно рассказали студентам о теоретических основах этой концепции и порядке внедрения инструментов и методик для оптимизации различных процессов. Гостям также были продемонстрированы действующая на предприятии модель операционного менеджмента, которая включает управление по нескольким основным направлениям, оценку рисков, эффективности и качества производства, и инструменты мониторинга процессов с применением бережливых технологий ...Далее»
Автор: ООО Группа Legrand Россия и СНГ Дата: 02-12-2020
|
Страницы:
«
1
2
3
4
5
6
7
8
9
10
11
12
13
14
15
»
16-23
|
|
 |
|
 |
|
|

